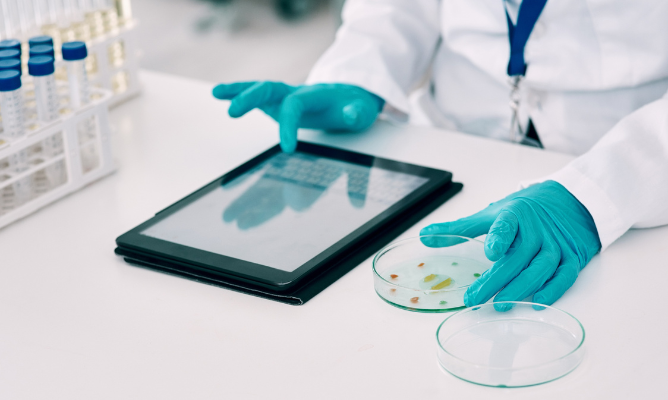
Legionella Risk Assessment and Testing Services in the UAE

URS Testing Laboratory LLC is accredited for ISO 17025 with EIAC. We are also registered CAB with the Emirates National Accreditation System (ENAS) in Abu Dhabi. Our laboratory is located in Jebel Ali, Dubai.
Over the past few years, we have established an enviable reputation for ourselves in certification with our experience being recognized and endorsed by local accreditation with the Emirates International Accreditation Centre (EIAC), as well as various local approvals by Governmental bodies such as Municipalities, OEMs, Ministries and major local corporate brands in the region.
Offering reliable Laboratory testing, Environment monitoring, Calibration & Training services in the Middle East
We are all the team experts and specialists of particular branches falls into
researches and diagnosis, ready to serve you at their best.